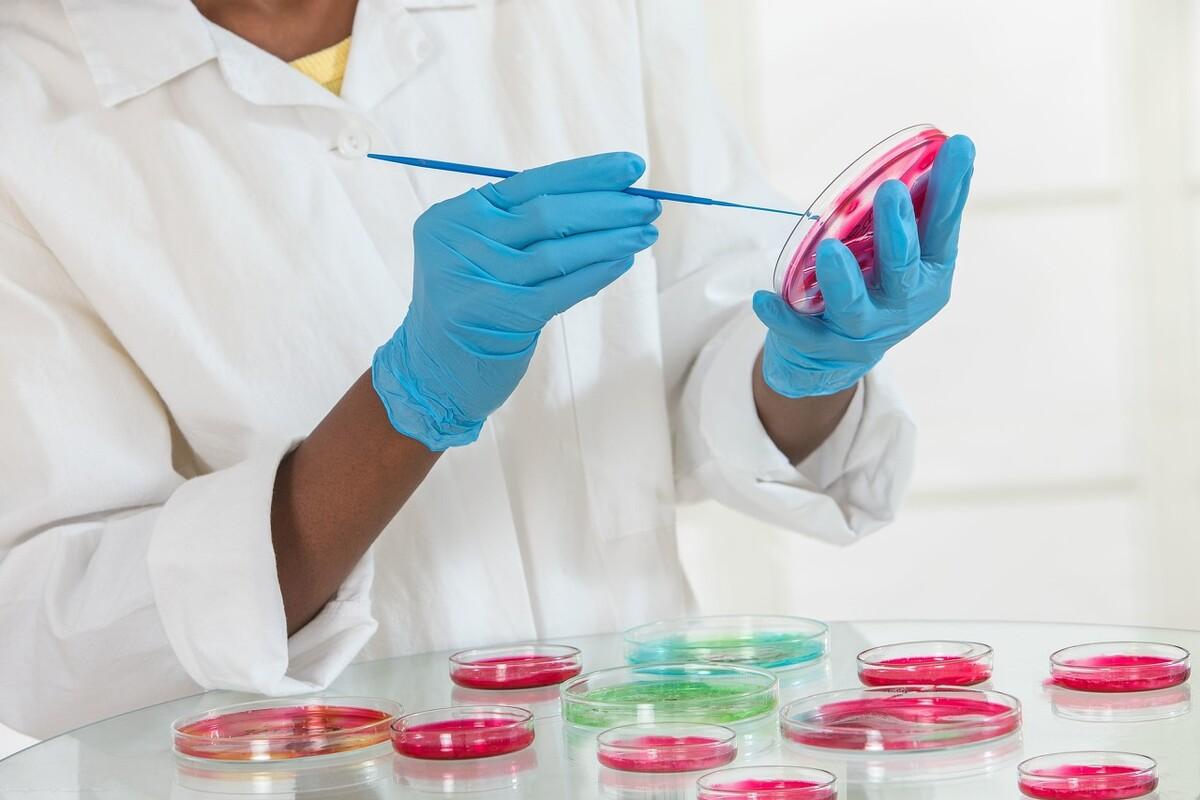
Image

简单制作培养基(上)
发布时间:2024-09-16
在微生物学研究中,培养基是支持细菌、真菌等微生物生长的关键工具。然而,对于普通家庭来说,制作专业的培养基似乎是一项遥不可及的任务。事实上,利用一些简单的日常食材和工具,我们也可以在家中制作出基本的培养基,开启一段奇妙的微生物探索之旅。
家庭制作培养基的关键在于模拟微生物生长所需的环境。最基本的培养基通常包含水、碳源、氮源和无机盐。以制作一种简单的酵母培养基为例,我们可以使用以下配方:
- 10克白糖
- 5克面包粉
- 1克酵母
- 100毫升水
将这些材料混合后,稍微加热至溶解,然后冷却至室温。这个简单的混合物就可以为酵母提供生长所需的营养。如果想要制作固体培养基,可以加入2%的琼脂粉。
在制作过程中,有几个关键点需要注意:
首先,清洁和消毒至关重要。虽然家庭环境难以达到实验室的无菌标准,但我们可以通过一些简单的方法来减少污染。例如,使用开水冲洗所有容器和工具,或者在使用前将它们放入烤箱中以120℃烘烤20分钟。
其次,温度控制也很重要。大多数微生物在25-30℃的环境中生长最佳。如果室温过低,可以考虑使用保温箱或在培养容器外包裹保温材料。
最后,观察和记录是不可或缺的。每天观察培养基的变化,记录微生物的生长情况,可以帮助我们更好地理解微生物的生长规律。
家庭制作培养基不仅能满足我们的好奇心,还具有重要的教育意义。对于学生来说,这是一次难得的实践机会,可以让他们亲身体验微生物学的基本原理。例如,通过比较不同配方培养基中微生物的生长情况,可以直观地展示微生物对营养的需求。
此外,家庭培养基还可以用于一些简单的科学实验。比如,我们可以尝试在培养基中加入不同的抗生素,观察其对细菌生长的影响,从而理解抗生素的作用机制。
虽然家庭制作的培养基无法达到专业实验室的标准,但它为我们打开了一扇通往微观世界的大门。通过这种简单而有趣的方式,我们不仅可以增进对微生物学的了解,还能培养科学思维和实验技能。在这个过程中,我们可能会遇到各种意想不到的问题和挑战,但正是这些经历,让我们更深刻地体会到科学研究的魅力。
所以,下次当你对微生物世界感到好奇时,不妨尝试在家中制作一个简单的培养基。你可能会惊讶地发现,微观世界其实离我们并不遥远,它就藏在我们日常生活的每一个角落。